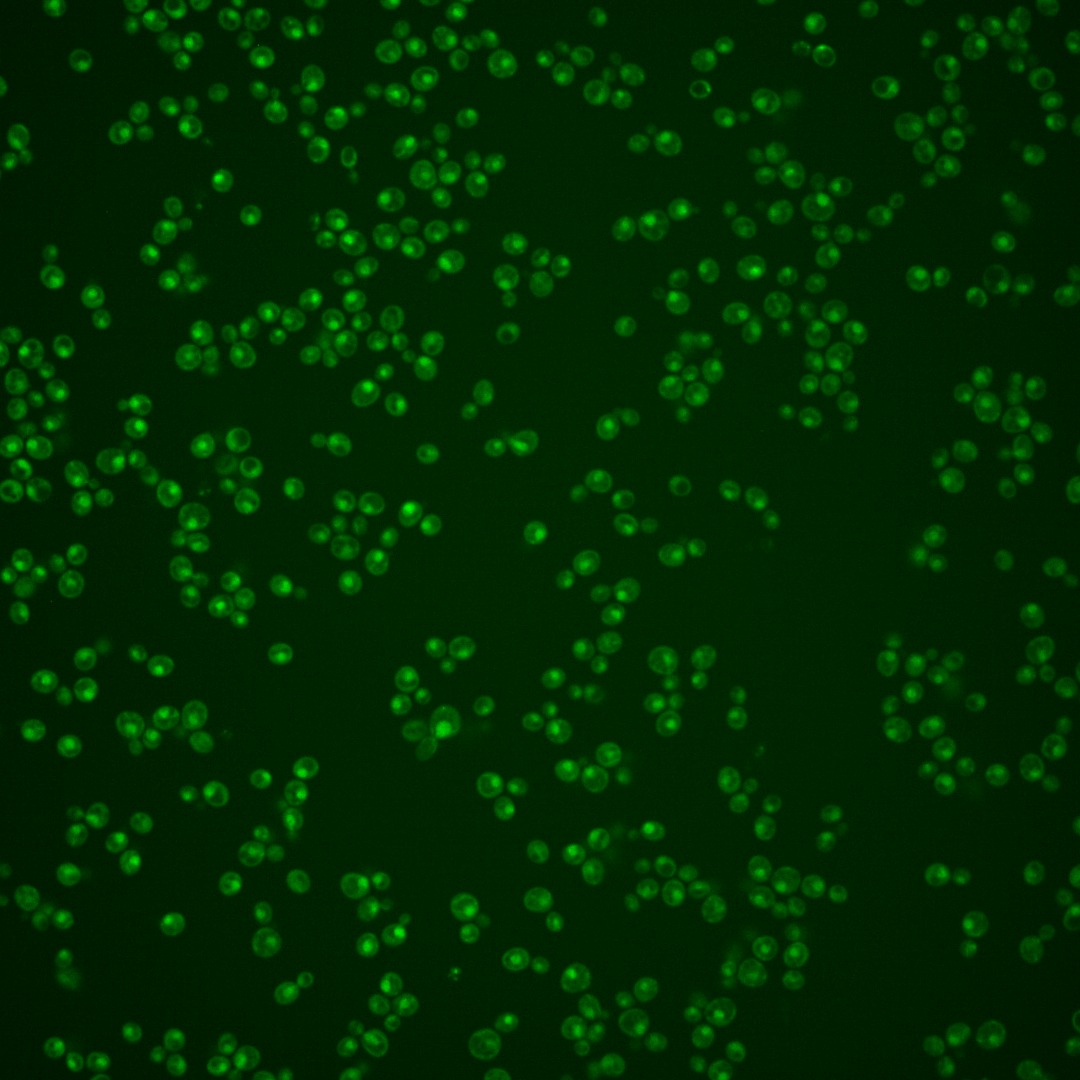
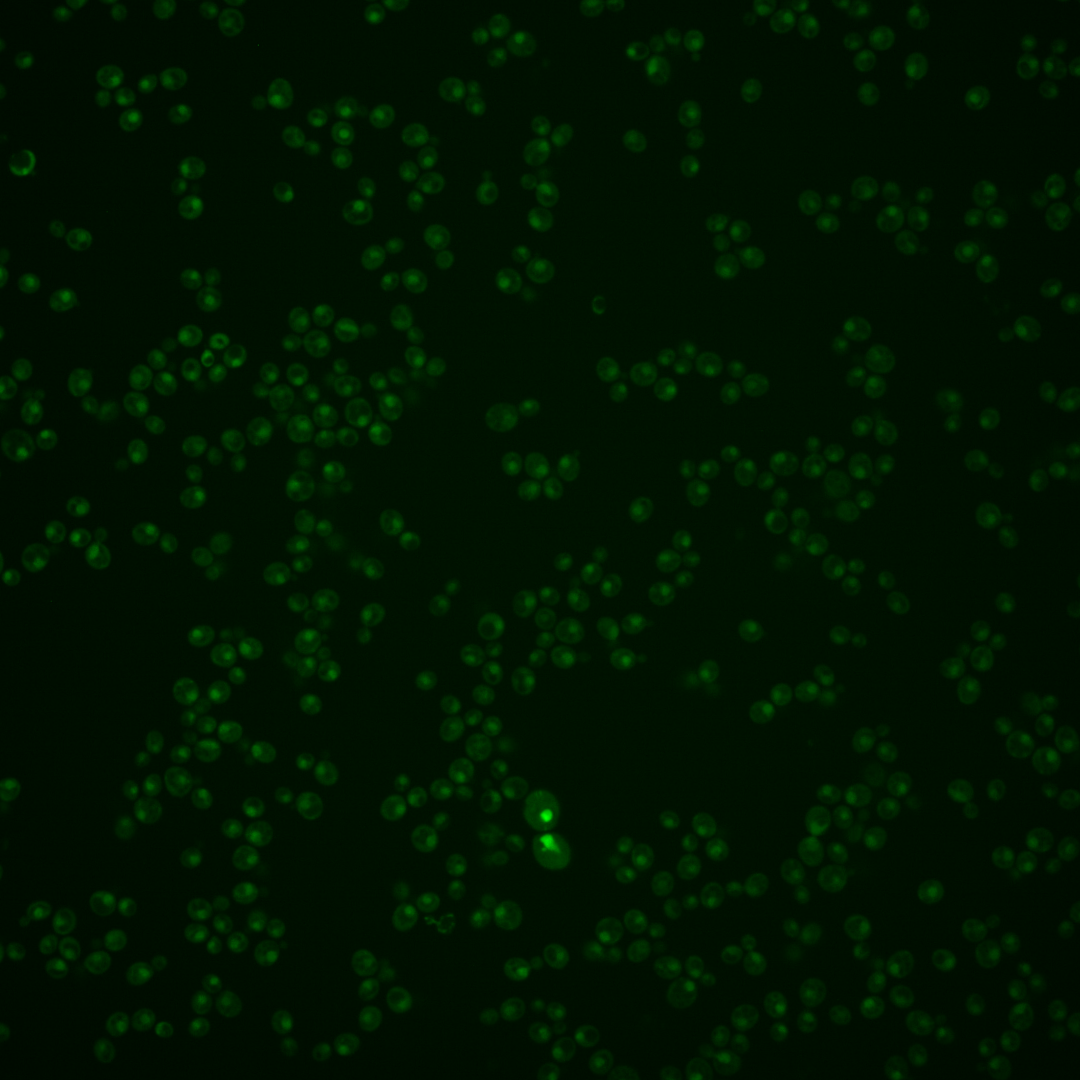
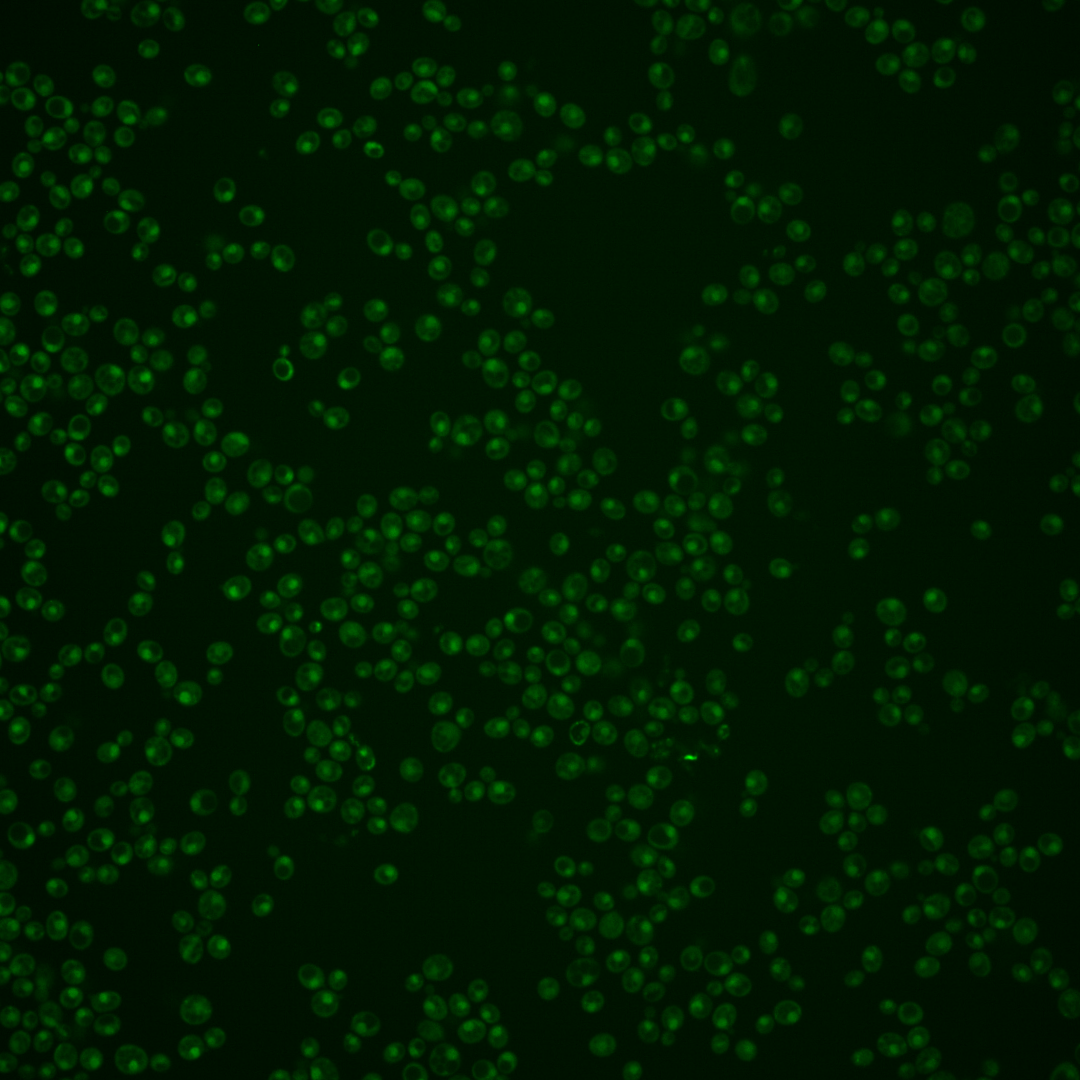
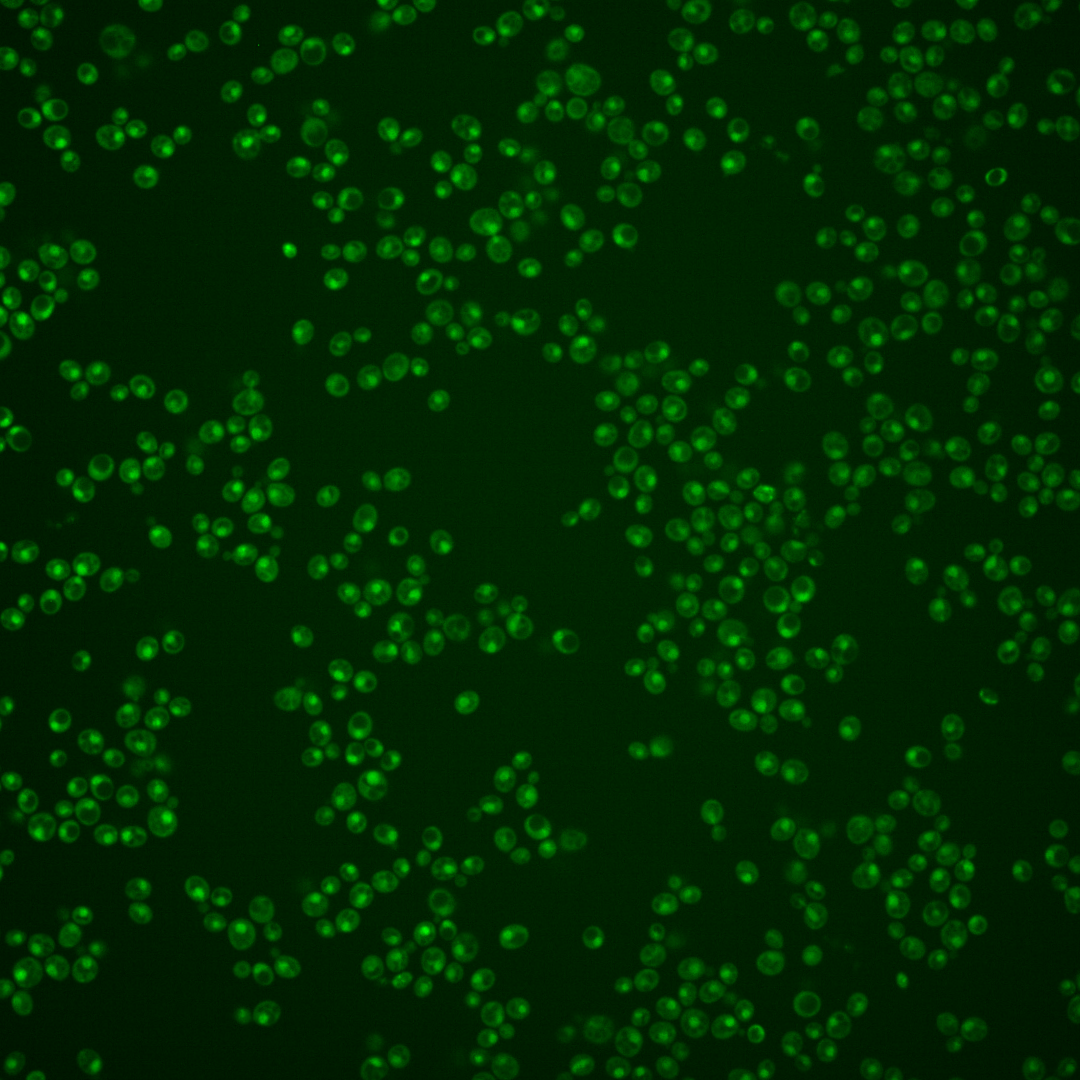
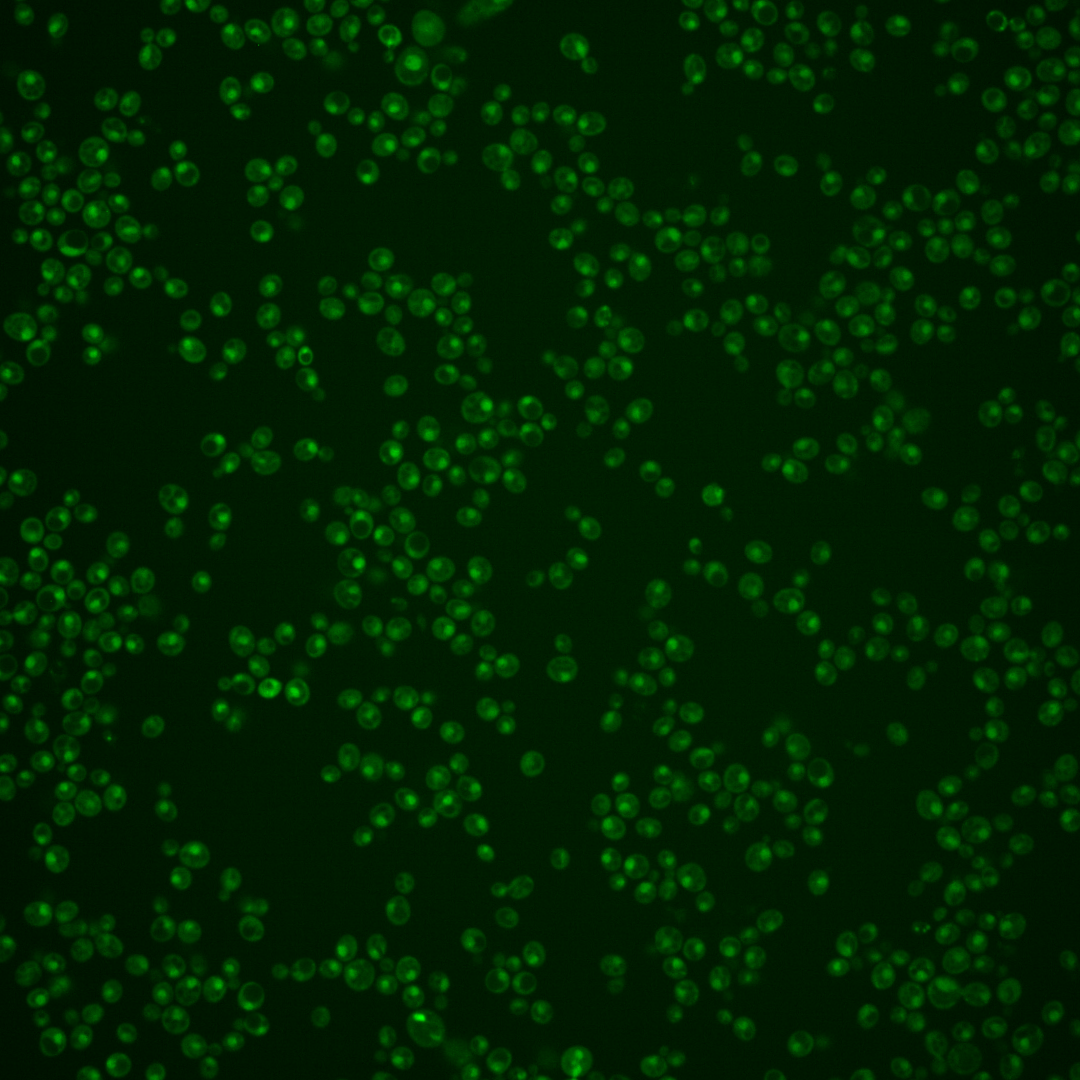
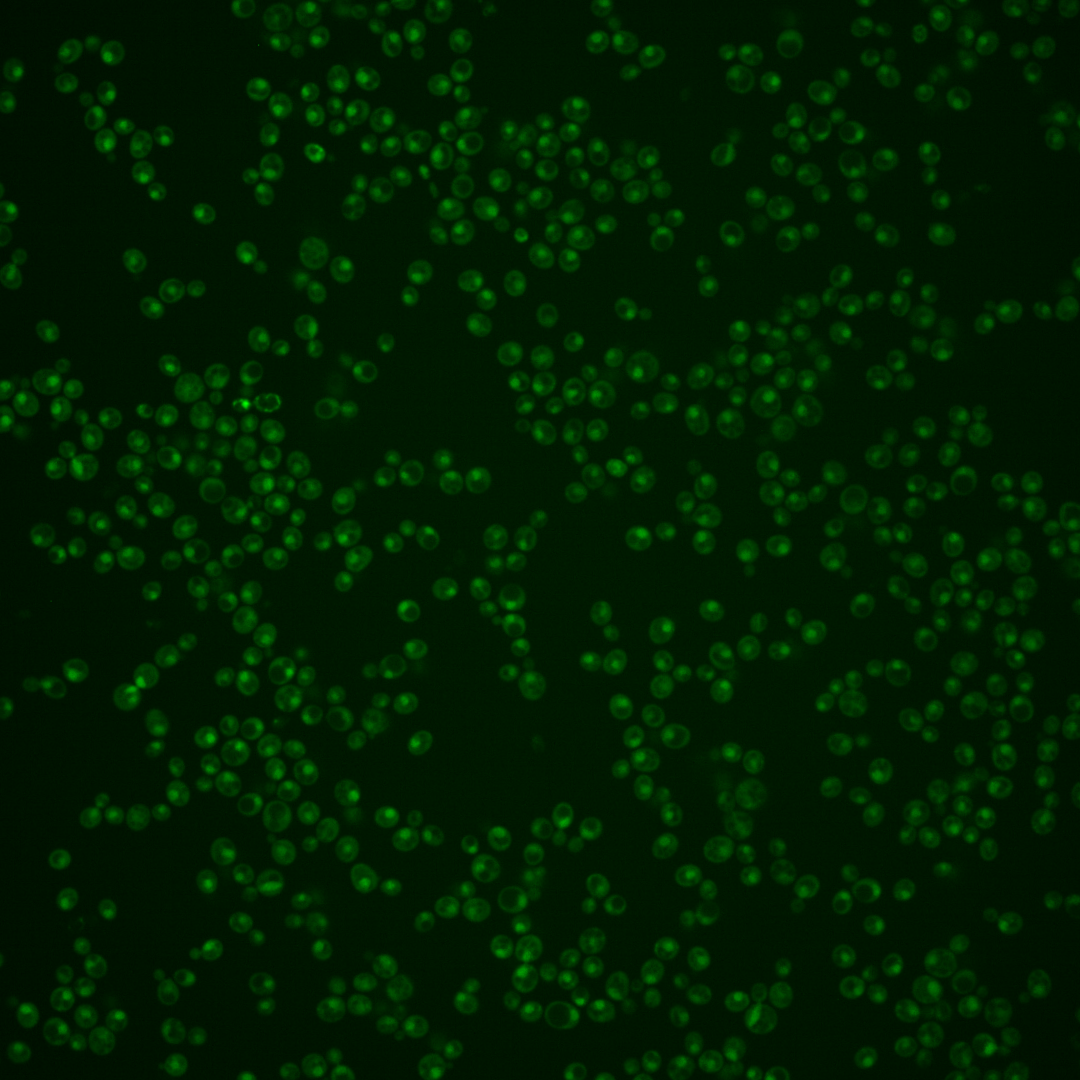

| Standard name | |
|---|---|
| Human Ortholog | |
| Description | Cyclin-like component of the RNA polymerase II holoenzyme; involved in phosphorylation of the RNA polymerase II C-terminal domain; forms a kinase-cyclin pair in the RNAPII holoenzyme with Ssn3p; required for both entry into and execution of the meiotic program; involved in glucose repression and telomere maintenance; cyclin homolog 35% identical to human cyclin C |
Micrographs




















































































Sub-cellular Localization
Yeast GFP Assignment
Protein Abundance
Localization Change
External localization resources
| ensLOC | DeepLoc | |||||||||||||||||||||||
|---|---|---|---|---|---|---|---|---|---|---|---|---|---|---|---|---|---|---|---|---|---|---|---|---|
| Localization | WT1 | WT2 | WT3 | RAP60 | RAP140 | RAP220 | RAP300 | RAP380 | RAP460 | RAP540 | RAP620 | RAP700 | HU80 | HU120 | HU160 | rpd3Δ_1 | rpd3Δ_2 | rpd3Δ_3 | WT1 | WT2 | WT3 | AF100 | AF140 | AF180 |
| Cortical Patches | 0 | 0 | 1 | 0 | 0 | 0 | 0 | 0 | 1 | 0 | 0 | 0 | 0 | 0 | 0 | 0 | 0 | 0 | 0 | 0 | 0 | 0 | 0 | 0 |
| Bud | 0 | 0 | 1 | 1 | 2 | 1 | 3 | 1 | 4 | 1 | 2 | 1 | 0 | 0 | 0 | 0 | 0 | 1 | 3 | 1 | 1 | 1 | 5 | 7 |
| Bud Neck | 0 | 0 | 3 | 0 | 3 | 2 | 1 | 2 | 1 | 0 | 0 | 1 | 0 | 0 | 0 | 0 | 0 | 0 | 0 | 0 | 1 | 2 | 0 | 2 |
| Bud Site | 2 | 0 | 0 | 0 | 1 | 4 | 10 | 7 | 5 | 5 | 9 | 6 | 0 | 0 | 0 | 0 | 0 | 0 | – | – | – | – | – | – |
| Cell Periphery | 0 | 0 | 0 | 0 | 0 | 0 | 1 | 0 | 0 | 0 | 0 | 0 | 0 | 0 | 0 | 0 | 0 | 0 | 0 | 0 | 0 | 0 | 0 | 0 |
| Cytoplasm | 8 | 3 | 19 | 16 | 43 | 18 | 23 | 22 | 22 | 30 | 14 | 19 | 14 | 35 | 34 | 46 | 31 | 42 | 4 | 0 | 4 | 2 | 3 | 4 |
| Endoplasmic Reticulum | 0 | 0 | 1 | 0 | 0 | 0 | 0 | 0 | 0 | 0 | 0 | 0 | 0 | 0 | 0 | 15 | 10 | 15 | 0 | 0 | 0 | 0 | 0 | 1 |
| Endosome | 2 | 0 | 0 | 2 | 3 | 4 | 0 | 2 | 0 | 0 | 0 | 7 | 1 | 1 | 2 | 5 | 5 | 6 | 2 | 2 | 1 | 1 | 6 | 6 |
| Golgi | 0 | 0 | 0 | 1 | 0 | 0 | 0 | 0 | 0 | 0 | 0 | 0 | 1 | 0 | 0 | 2 | 2 | 2 | 0 | 0 | 1 | 1 | 4 | 0 |
| Mitochondria | 69 | 1 | 3 | 25 | 36 | 78 | 154 | 105 | 220 | 176 | 197 | 129 | 0 | 0 | 0 | 12 | 8 | 23 | 3 | 1 | 3 | 2 | 10 | 7 |
| Nucleus | 163 | 81 | 162 | 155 | 211 | 170 | 191 | 187 | 194 | 244 | 184 | 186 | 90 | 170 | 211 | 347 | 247 | 323 | 168 | 80 | 143 | 104 | 123 | 129 |
| Nuclear Periphery | 0 | 0 | 1 | 0 | 1 | 1 | 1 | 0 | 1 | 0 | 0 | 1 | 0 | 0 | 0 | 1 | 0 | 1 | 1 | 0 | 0 | 1 | 1 | 1 |
| Nucleolus | 13 | 0 | 1 | 0 | 0 | 2 | 1 | 0 | 1 | 2 | 2 | 2 | 0 | 0 | 0 | 0 | 2 | 2 | 4 | 5 | 17 | 15 | 18 | 15 |
| Peroxisomes | 0 | 0 | 0 | 0 | 0 | 0 | 0 | 0 | 1 | 0 | 0 | 0 | 0 | 0 | 0 | 0 | 0 | 0 | 0 | 0 | 0 | 0 | 0 | 0 |
| SpindlePole | 1 | 1 | 13 | 10 | 7 | 2 | 4 | 16 | 2 | 10 | 1 | 5 | 2 | 6 | 5 | 7 | 9 | 3 | 7 | 2 | 6 | 8 | 12 | 11 |
| Vac/Vac Membrane | 11 | 6 | 1 | 0 | 7 | 3 | 4 | 1 | 9 | 8 | 8 | 37 | 5 | 8 | 8 | 25 | 20 | 35 | 21 | 14 | 27 | 17 | 33 | 25 |
| Unique Cell Count | 200 | 90 | 190 | 189 | 282 | 226 | 276 | 257 | 312 | 347 | 280 | 297 | 109 | 209 | 254 | 421 | 309 | 417 | 219 | 110 | 215 | 161 | 228 | 222 |
| Labelled Cell Count | 269 | 92 | 206 | 210 | 314 | 285 | 393 | 343 | 461 | 476 | 417 | 394 | 113 | 220 | 260 | 460 | 334 | 453 | 219 | 110 | 215 | 161 | 228 | 222 |
Yeast GFP Assignment
Protein Abundance
| Screen | WT1 | WT2 | WT3 | RAP60 | RAP140 | RAP220 | RAP300 | RAP380 | RAP460 | RAP540 | RAP620 | RAP700 | HU80 | HU120 | HU160 | rpd3Δ_1 | rpd3Δ_2 | rpd3Δ_3 | AF100 | AF140 | AF180 |
|---|---|---|---|---|---|---|---|---|---|---|---|---|---|---|---|---|---|---|---|---|---|
| Mean Cell GFP Intensity (1e-4) | 4.0 | 5.5 | 4.9 | 5.2 | 5.0 | 4.0 | 3.8 | 4.5 | 3.7 | 4.0 | 3.6 | 4.2 | 5.8 | 6.0 | 5.9 | 6.6 | 6.9 | 6.5 | 5.5 | 6.0 | 6.1 |
| Std Deviation (1e-4) | 0.7 | 1.1 | 0.8 | 1.7 | 1.9 | 1.1 | 1.2 | 1.6 | 0.8 | 1.1 | 0.8 | 1.0 | 1.3 | 1.4 | 1.4 | 1.5 | 1.7 | 1.6 | 1.3 | 1.8 | 1.7 |
| Intensity Change (Log2) | – | – | – | 0.07 | 0.02 | -0.29 | -0.39 | -0.12 | -0.43 | -0.3 | -0.46 | -0.22 | 0.25 | 0.3 | 0.26 | 0.43 | 0.49 | 0.4 | 0.15 | 0.29 | 0.32 |
Localization Change
| Localization | RAP60 | RAP140 | RAP220 | RAP300 | RAP380 | RAP460 | RAP540 | RAP620 | RAP700 | HU80 | HU120 | HU160 | rpd3Δ_1 | rpd3Δ_2 | rpd3Δ_3 |
|---|---|---|---|---|---|---|---|---|---|---|---|---|---|---|---|
| Cortical Patches | 0 | 0 | 0 | 0 | 0 | 0 | 0 | 0 | 0 | 0 | 0 | 0 | 0 | 0 | 0 |
| Bud | 0 | 0 | 0 | 0 | 0 | 0 | 0 | 0 | 0 | 0 | 0 | 0 | 0 | 0 | 0 |
| Bud Neck | 0 | 0 | 0 | 0 | 0 | 0 | 0 | 0 | 0 | 0 | 0 | 0 | 0 | 0 | 0 |
| Bud Site | 0 | 0 | 0 | 0 | 0 | 0 | 0 | 0 | 0 | 0 | 0 | 0 | 0 | 0 | 0 |
| Cell Periphery | 0 | 0 | 0 | 0 | 0 | 0 | 0 | 0 | 0 | 0 | 0 | 0 | 0 | 0 | 0 |
| Cytoplasm | -0.5 | 1.7 | -0.7 | -0.6 | -0.5 | -1.2 | -0.5 | -2.1 | -1.4 | 0.8 | 2.0 | 1.1 | 0.3 | 0 | 0 |
| Endoplasmic Reticulum | 0 | 0 | 0 | 0 | 0 | 0 | 0 | 0 | 0 | 0 | 0 | 0 | 0 | 0 | 2.2 |
| Endosome | 0 | 0 | 0 | 0 | 0 | 0 | 0 | 0 | 0 | 0 | 0 | 0 | 0 | 0 | 0 |
| Golgi | 0 | 0 | 0 | 0 | 0 | 0 | 0 | 0 | 0 | 0 | 0 | 0 | 0 | 0 | 0 |
| Mitochondria | 4.3 | 4.3 | 0 | 0 | 0 | 0 | 0 | 0 | 0 | 0 | 0 | 0 | 0 | 0 | 2.2 |
| Nucleus | -0.9 | -2.7 | -2.5 | -4.0 | -3.2 | -5.5 | -3.9 | -4.7 | -5.4 | -0.6 | -1.0 | -0.6 | -0.9 | -1.5 | -2.2 |
| Nuclear Periphery | 0 | 0 | 0 | 0 | 0 | 0 | 0 | 0 | 0 | 0 | 0 | 0 | 0 | 0 | 0 |
| Nucleolus | 0 | 0 | 0 | 0 | 0 | 0 | 0 | 0 | 0 | 0 | 0 | 0 | 0 | 0 | 0 |
| Peroxisomes | 0 | 0 | 0 | 0 | 0 | 0 | 0 | 0 | 0 | 0 | 0 | 0 | 0 | 0 | 0 |
| SpindlePole | -0.6 | -2.3 | 0 | 0 | 0 | 0 | 0 | 0 | 0 | -1.9 | -1.9 | -2.6 | -3.3 | -2.1 | -4.4 |
| Vacuole | 0 | 0 | 0 | 0 | 0 | 0 | 0 | 0 | 4.8 | 0 | 0 | 0 | 3.1 | 3.2 | 3.8 |
External localization resources
Images






























Protein Concentration and Protein Localization Data
| R1 | R2 | R3 | ||||||||||||||||
|---|---|---|---|---|---|---|---|---|---|---|---|---|---|---|---|---|---|---|
| G1 Pre-START | G1 Post-START | S/G2 | Metaphase | Anaphase | Telophase | G1 Pre-START | G1 Post-START | S/G2 | Metaphase | Anaphase | Telophase | G1 Pre-START | G1 Post-START | S/G2 | Metaphase | Anaphase | Telophase | |
| Concentration | 0.3919 | 0.5642 | 0.398 | 0.0122 | 0.0435 | 0.4186 | 0.5897 | 0.7943 | 0.7015 | 0.5021 | 0.1138 | 0.6051 | 0.5885 | 0.0259 | 0.7709 | 0.5164 | 0.6274 | 0.2324 |
| Actin | 0.0098 | 0.0001 | 0.0011 | 0.0002 | 0.0052 | 0.0099 | 0.01 | 0 | 0.0028 | 0 | 0.0001 | 0.0005 | 0.0617 | 0.0001 | 0.0161 | 0.0153 | 0.003 | 0.0122 |
| Bud | 0.0003 | 0.0018 | 0 | 0.0027 | 0.0001 | 0.0001 | 0.0032 | 0 | 0.0048 | 0 | 0 | 0 | 0.0006 | 0.0002 | 0.0005 | 0.0003 | 0.0005 | 0.0001 |
| Bud Neck | 0.0017 | 0.0006 | 0.0003 | 0.0005 | 0.0012 | 0.0039 | 0.0056 | 0.0003 | 0.0004 | 0.0001 | 0.0007 | 0.001 | 0.0063 | 0.0004 | 0.0015 | 0.0008 | 0.0019 | 0.0016 |
| Bud Periphery | 0.0005 | 0.0002 | 0 | 0.0004 | 0.0003 | 0.0001 | 0.0018 | 0 | 0.0013 | 0 | 0 | 0.0001 | 0.0011 | 0.0001 | 0.0007 | 0.0007 | 0.0014 | 0.0001 |
| Bud Site | 0.0006 | 0.001 | 0.0001 | 0.0001 | 0.0003 | 0.0001 | 0.0027 | 0.0001 | 0.0008 | 0 | 0 | 0.0001 | 0.0095 | 0.0005 | 0.0159 | 0.0005 | 0.0038 | 0.0001 |
| Cell Periphery | 0.0001 | 0 | 0 | 0 | 0 | 0 | 0.0004 | 0 | 0 | 0 | 0 | 0 | 0.0007 | 0 | 0.0007 | 0.0001 | 0.0006 | 0 |
| Cytoplasm | 0.0207 | 0.02 | 0.0046 | 0.0097 | 0.0037 | 0.0009 | 0.0086 | 0.0023 | 0.002 | 0.0009 | 0.0036 | 0.0005 | 0.0058 | 0.0057 | 0.0113 | 0.0115 | 0.0022 | 0.0028 |
| Cytoplasmic Foci | 0.0046 | 0.0016 | 0.0002 | 0.0003 | 0.0031 | 0.0005 | 0.0104 | 0.0001 | 0.0013 | 0 | 0.0001 | 0.0004 | 0.041 | 0.0024 | 0.0087 | 0.0008 | 0.0009 | 0.001 |
| Eisosomes | 0.0002 | 0 | 0 | 0 | 0.0001 | 0 | 0.0003 | 0 | 0 | 0 | 0 | 0 | 0.002 | 0 | 0.0001 | 0.0001 | 0.0002 | 0 |
| Endoplasmic Reticulum | 0.0044 | 0.0007 | 0.0036 | 0.0004 | 0.0019 | 0.0011 | 0.0046 | 0.0002 | 0.0003 | 0 | 0.0001 | 0.0001 | 0.0056 | 0.0004 | 0.0182 | 0.0013 | 0.0014 | 0.0033 |
| Endosome | 0.0238 | 0.0032 | 0.0028 | 0.0003 | 0.0246 | 0.0044 | 0.0144 | 0.0002 | 0.0038 | 0 | 0.0001 | 0.0012 | 0.0246 | 0.0004 | 0.0032 | 0.0085 | 0.007 | 0.0062 |
| Golgi | 0.0026 | 0 | 0.0002 | 0 | 0.0031 | 0.0013 | 0.0033 | 0 | 0.0009 | 0 | 0 | 0.0005 | 0.0115 | 0 | 0.0017 | 0.006 | 0.0022 | 0.0023 |
| Lipid Particles | 0.006 | 0.0001 | 0.0003 | 0 | 0.0157 | 0.0004 | 0.0186 | 0 | 0.0018 | 0 | 0 | 0.0015 | 0.0218 | 0.0001 | 0.0038 | 0.0014 | 0.0058 | 0.0019 |
| Mitochondria | 0.0022 | 0.0007 | 0.0003 | 0.0003 | 0.0122 | 0.0004 | 0.0163 | 0.0002 | 0.0012 | 0.0001 | 0.0001 | 0.0019 | 0.0134 | 0.0002 | 0.0014 | 0.004 | 0.0045 | 0.0005 |
| None | 0.0344 | 0.0168 | 0.0024 | 0.0185 | 0.0029 | 0.0134 | 0.028 | 0.0091 | 0.0073 | 0.0001 | 0.0427 | 0.0065 | 0.0055 | 0.002 | 0.0016 | 0.0059 | 0.001 | 0.0014 |
| Nuclear Periphery | 0.0353 | 0.0127 | 0.0136 | 0.0224 | 0.0279 | 0.0068 | 0.0326 | 0.0089 | 0.0118 | 0.0008 | 0.0062 | 0.0044 | 0.0211 | 0.0075 | 0.01 | 0.0067 | 0.029 | 0.0137 |
| Nucleolus | 0.0101 | 0.0108 | 0.0063 | 0.0069 | 0.013 | 0.018 | 0.0215 | 0.009 | 0.0085 | 0.0048 | 0.0323 | 0.0208 | 0.0079 | 0.0082 | 0.0062 | 0.009 | 0.022 | 0.0173 |
| Nucleus | 0.8018 | 0.8996 | 0.9487 | 0.9183 | 0.8429 | 0.9156 | 0.7837 | 0.9476 | 0.934 | 0.9899 | 0.8947 | 0.9435 | 0.7137 | 0.9432 | 0.86 | 0.9135 | 0.8936 | 0.9152 |
| Peroxisomes | 0.0013 | 0 | 0 | 0 | 0.0058 | 0.0001 | 0.0069 | 0 | 0.0072 | 0 | 0 | 0.0022 | 0.0175 | 0 | 0.0047 | 0.0003 | 0.0005 | 0.0005 |
| Punctate Nuclear | 0.0357 | 0.0279 | 0.0148 | 0.0183 | 0.0327 | 0.0224 | 0.0227 | 0.0217 | 0.009 | 0.0033 | 0.0189 | 0.0145 | 0.0249 | 0.0283 | 0.0322 | 0.0116 | 0.0106 | 0.0192 |
| Vacuole | 0.0022 | 0.0016 | 0.0005 | 0.0003 | 0.0013 | 0.0003 | 0.0028 | 0.0002 | 0.0004 | 0 | 0.0001 | 0.0002 | 0.0022 | 0.0002 | 0.0011 | 0.0007 | 0.0049 | 0.0003 |
| Vacuole Periphery | 0.0017 | 0.0003 | 0.0003 | 0.0003 | 0.0019 | 0.0002 | 0.0018 | 0.0001 | 0.0003 | 0 | 0.0001 | 0.0002 | 0.0016 | 0.0001 | 0.0004 | 0.0008 | 0.0031 | 0.0003 |
Sequencing Data
| R1 | R2 | |||||||||
|---|---|---|---|---|---|---|---|---|---|---|
| G1 Post-START | S/G2 | Metaphase | Anaphase | Telophase | G1 Post-START | S/G2 | Metaphase | Anaphase | Telophase | |
| Gene Expression | 14.1899 | 13.1923 | 6.0241 | 14.1252 | 10.3028 | 2.2691 | 11.7996 | 11.0803 | 10.1217 | 13.1568 |
| Translational Efficiency | 0.5295 | 0.5545 | 1.031 | 0.4503 | 0.4669 | 4.1802 | 0.6354 | 0.4584 | 0.5392 | 0.5199 |
Hit Data
| Dataset | Hit |
|---|---|
| Protein Concentration | ✘ |
| Protein Localization | ✘ |
| Gene Expression | ✘ |
| Translational Efficiency | ✘ |
Endocytosis
| Temp | Actin Patch (Sac6-tdTomato) | Cortical Patch (Sla1-GFP) | Late Endosome (Snf7-GFP) | Vacuole (Vph1-GFP) |
|---|---|---|---|---|
| 37℃ | ||||
| RT |
Cell Cycle Omics
CYCLoPs (Ssn8-GFP)
| Gene / Allele | Actin Patch (Sac6-tdTomato) | Cortical Patch (Sla1-GFP) | Late Endosome (Snf7-GFP) | Vacuole (Sac6-tdTomato) |
|---|
| Gene | Images |
|---|
| Gene | Images |
|---|
Images are not yet available
Images are not yet available